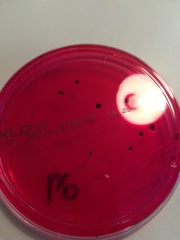
Salmonella
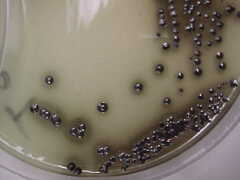
Salmonella

Salmonella: taxon details and analytics
- Domain
- Kingdom
- Bacteria
- Phylum
- Proteobacteria
- Class
- Gammaproteobacteria
- Order
- Enterobacteriales
- Family
- Enterobacteriaceae
- Genus
- Salmonella
- Species
- Scientific Name
- Salmonella
Salmonella in languages:
- Estonian
- Salmonellabakter